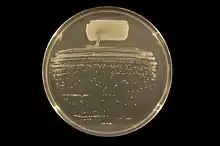

Rhizobium
Rhizobium is a genus of Gram-negative soil bacteria that fix nitrogen. Rhizobium species form an endosymbiotic nitrogen-fixing association with roots of legumes and Parasponia.
| Rhizobium | |
|---|---|
![]() | |
| Rhizobium tropici on an agar plate. | |
| Scientific classification | |
| Kingdom: | Bacteria |
| Phylum: | |
| Class: | |
| Order: | |
| Family: | |
| Genus: | Rhizobium Frank 1889 |
| Type species | |
| Rhizobium leguminosarum | |
| Species[1] | |
The bacteria colonize plant cells within root nodules, where they convert atmospheric nitrogen into ammonia using the enzyme nitrogenase and then provide organic nitrogenous compounds such as glutamine or ureides to the plant. The plant, in turn, provides the bacteria with organic compounds made by photosynthesis.[2] This mutually beneficial relationship is true of all of the rhizobia, of which the genus Rhizobium is a typical example. Rhizobium is also capable to solubilize phosphorus.[3]
The taxon has largely subsumed genera Agrobacterium Conn 1942 and Allorhizobium following in phelogenetic research from the late 1990s to the early 2000s when the two genera were shown to be not very different from Rhizobium. A confusing result is that Agrobacterium tumefaciens, now Rhizobium radiobacter, remains as the type species of Agrobacterium.[4] The division of genera under Rhizobiaceae remains fluid.
History
Martinus Beijerinck was the first to isolate and cultivate a microorganism from the nodules of legumes in 1888. He named it Bacillus radicicola, which is now placed in Bergey's Manual of Determinative Bacteriology under the genus Rhizobium.
Research
Rhizobium forms a symbiotic relationship with certain plants such as legumes, fixing nitrogen from the air into ammonia, which acts as a natural fertilizer for the plants. Current research is being conducted by Agricultural Research Service microbiologists to discover a way to use Rhizobium’s biological nitrogen fixation. This research involves the genetic mapping of various rhizobial species with their respective symbiotic plant species, like alfalfa or soybean. The goal of this research is to increase the plants’ productivity without using fertilizers.[5]
In molecular biology, Rhizobium has also been identified as a contaminant of DNA extraction kit reagents and ultrapure water systems, which may lead to its erroneous appearance in microbiota or metagenomic datasets.[6] The presence of nitrogen fixing bacteria as contaminants may be due to the use of nitrogen gas in ultra-pure water production to inhibit microbial growth in storage tanks.[7]
Species
- Rhizobium aegyptiacum Shamseldin et al. 2016
- Rhizobium aggregatum (Hirsch and Müller 1986) Kaur et al. 2011[8]
- Rhizobium alamii Berge et al. 2009
- Rhizobium altiplani Baraúna et al. 2016
- Rhizobium alvei Sheu et al. 2015
- Rhizobium anhuiense Zhang et al. 2015
- Rhizobium azibense Mnasri et al. 2014
- Rhizobium azooxidifex Behrendt et al. 2016
- Rhizobium bangladeshense Harun-or Rashid et al. 2015
- symbiovar trifolii
- symbiovar viciae
- Rhizobium binae Harun-or Rashid et al. 2015
- Rhizobium calliandrae Rincón-Rosales et al. 2013
- Rhizobium capsici Lin et al. 2015
- Rhizobium cauense Liu et al. 2015
- Rhizobium cellulosilyticum García-Fraile et al. 2007
- Rhizobium daejeonense Quan et al. 2005
- Rhizobium ecuadorense Ribeiro et al. 2015
- Rhizobium endolithicum Parag et al. 2014
- Rhizobium endophyticum López-López et al. 2010
- Rhizobium etli Segovia et al. 1993[9]
- symbiovar mimosae
- symbiovar phaseoli
- Rhizobium fabae Tian et al. 2008
- Rhizobium flavum Gu et al. 2014
- Rhizobium freirei Dall'Agnol et all. 2013
- Rhizobium gallicum Amarger et al. 1997
- Rhizobium grahamii López-López et al. 2011
- Rhizobium hainanense Chen et al. 1997
- Rhizobium halophytocola Bibi et al. 2012
- Rhizobium halotolerans Diange and Lee 2013[12]
- Rhizobium indigoferae Wei et al. 2002
- Rhizobium jaguaris Rincón-Rosales et al. 2013
- Rhizobium kunmingense Shen et al. 2010
- Rhizobium laguerreae Saïdi et al. 2014
- Rhizobium leguminosarum (Frank 1879) Frank 1889
- symbiovar trifolii
- symbiovar viciae
- Rhizobium lemnae Kittiwongwattana & Thawai 2014
- Rhizobium lentis Harun-or Rashid et al. 2015
- Rhizobium leucaenae Ribeiro et al. 2011
- Rhizobium loessense Wei et al. 2003
- Rhizobium lusitanum Valverde et al. 2006
- "Candidatus Rhizobium massiliae" Greub et al. 2004.
- Rhizobium mayense Rincón-Rosales et al. 2013
- Rhizobium mesoamericanum López-López et al. 2011
- Rhizobium mesosinicum Lin et al. 2009
- Rhizobium metallidurans Grison et al. 2015
- Rhizobium miluonense Gu et al. 2008
- Rhizobium mongolense Herr Baronn O. Vonn Berkum et al. 1998[11]
- Rhizobium multihospitium Han et al. 2008
- Rhizobium naphthalenivorans Kaiya et al. 2012
- Rhizobium oryzicola Zhang et al. 2015
- Rhizobium pakistanensis Khalid et al. 2014
- Rhizobium paranaense Dall'Agnol et al. 2014
- Rhizobium petrolearium Zhang et al. 2012
- Rhizobium phaseoli Dangeard 1926 emend. Ramírez-Bahena et al. 2008
- Rhizobium phenanthrenilyticum Wen et al. 2011
- Rhizobium pisi Ramírez-Bahena et al. 2008
- Rhizobium pongamiae Kesari et al. 2013[14]
- Rhizobium populi Rozahon et al. 2014
- Rhizobium qilianshanense Xu et al. 2013[15]
- Rhizobium rhizogenes (Riker et al. 1930) Young et al. 2001
- Rhizobium rhizoryzae Zhang et al. 2014
- Rhizobium rosettiformans Kaur et al. 2011
- Rhizobium selenitireducens corrig. Hunter et al. 2008
- Rhizobium smilacinae Zhang et al. 2014
- Rhizobium soli Yoon et al. 2010
- Rhizobium sophorae Jiao et al. 2014
- Rhizobium sophoriradicis Jiao et al. 2014
- Rhizobium straminoryzae Lin et al. 2014
- Rhizobium subbaraonis Ramana et al. 2013
- Rhizobium sullae Squartini et al. 2002
- Rhizobium tarimense Turdahon et al. 2012[16]
- Rhizobium tibeticum Hou et al. 2009
- Rhizobium tropici Martínez-Romero et al. 1991
- Rhizobium tubonense Zhang et al. 2011
- Rhizobium vallis Wang et all. 2011[17]
- Rhizobium yanglingense Tan et al. 2001[11]
- Rhizobium yantingense Chen et al. 2015
Phylogeny
The currently accepted taxonomy is based on the List of Prokaryotic names with Standing in Nomenclature (LPSN) [1] and National Center for Biotechnology Information (NCBI)[18] and the phylogeny is based on 16S rRNA-based LTP release 106 by The All-Species Living Tree Project.[19]
| ||||||||||||||||||||||||||||||||||||||||||||||||||||||||||||||||||||||||||||||||||||||||||||||||||||||||||||||||||||||||||||||||||||||||||||||||||||||||||||||||
References
- Euzéby JP. "Rhizobium". List of Prokaryotic names with Standing in Nomenclature (LPSN). Retrieved 2012-05-02.
- Sawada H, Kuykendall LD, Young JM (June 2003). "Changing concepts in the systematics of bacterial nitrogen-fixing legume symbionts". The Journal of General and Applied Microbiology. 49 (3): 155–79. doi:10.2323/jgam.49.155. PMID 12949698.
- Sridevi M, Mallaiah KV (March 2009). "Phosphate solubilization by Rhizobium strains". Indian Journal of Microbiology. 49 (1): 98–102. doi:10.1007/s12088-009-0005-1. PMC 3450048. PMID 23100757.
- Young JM, Kuykendall LD, Martínez-Romero E, Kerr A, Sawada H (January 2001). "A revision of Rhizobium Frank 1889, with an emended description of the genus, and the inclusion of all species of Agrobacterium Conn 1942 and Allorhizobium undicola de Lajudie et al. 1998 as new combinations: Rhizobium radiobacter, R. rhizogenes, R. rubi, R. undicola and R. vitis". International Journal of Systematic and Evolutionary Microbiology. 51 (Pt 1): 89–103. doi:10.1099/00207713-51-1-89. PMID 11211278.
- "Marvelous Microbe Collections Accelerate Discoveries To Protect People, Plants—and More!". Agricultural Research. United States Department of Agriculture. January 2010. Retrieved 10 August 2018.
- Salter SJ, Cox MJ, Turek EM, Calus ST, Cookson WO, Moffatt MF, et al. (November 2014). "Reagent and laboratory contamination can critically impact sequence-based microbiome analyses". BMC Biology. 12: 87. bioRxiv 10.1101/007187. doi:10.1186/s12915-014-0087-z. PMC 4228153. PMID 25387460.
- Kulakov LA, McAlister MB, Ogden KL, Larkin MJ, O'Hanlon JF (April 2002). "Analysis of bacteria contaminating ultrapure water in industrial systems". Applied and Environmental Microbiology. 68 (4): 1548–55. doi:10.1128/AEM.68.4.1548-1555.2002. PMC 123900. PMID 11916667.
- NOTE: This strain was formerly named Blastobacter aggregatus.
- NOTE: This species was formerly known as R. leguminosarum sv. phaseoli.
- Amarger N, Macheret V, Laguerre G (October 1997). "Rhizobium gallicum sp. nov. and Rhizobium giardinii sp. nov., from Phaseolus vulgaris nodules". International Journal of Systematic Bacteriology. 47 (4): 996–1006. doi:10.1099/00207713-47-4-996. PMID 9336898.
- Silva C, Vinuesa P, Eguiarte LE, Souza V, Martínez-Romero E (November 2005). "Evolutionary genetics and biogeographic structure of Rhizobium gallicum sensu lato, a widely distributed bacterial symbiont of diverse legumes". Molecular Ecology. 14 (13): 4033–50. doi:10.1111/j.1365-294X.2005.02721.x. PMID 16262857. S2CID 16668742.
- Diange EA, Lee SS (June 2013). "Rhizobium halotolerans sp. nov., Isolated from chloroethylenes contaminated soil". Current Microbiology. 66 (6): 599–605. doi:10.1007/s00284-013-0313-x. PMID 23377488. S2CID 17809044.
- Marek-Kozaczuk M, Leszcz A, Wielbo J, Wdowiak-Wróbel S, Skorupska A (June 2013). "Rhizobium pisi sv. trifolii K3.22 harboring nod genes of the Rhizobium leguminosarum sv. trifolii cluster". Systematic and Applied Microbiology. 36 (4): 252–8. doi:10.1016/j.syapm.2013.01.005. PMID 23507586.
- Kesari V, Ramesh AM, Rangan L (2013). "Rhizobium pongamiae sp. nov. from root nodules of Pongamia pinnata". BioMed Research International. 2013: 165198. doi:10.1155/2013/165198. PMC 3783817. PMID 24078904.
- Xu L, Zhang Y, Deng ZS, Zhao L, Wei XL, Wei GH (March 2013). "Rhizobium qilianshanense sp. nov., a novel species isolated from root nodule of Oxytropis ochrocephala Bunge in China". Antonie van Leeuwenhoek. 103 (3): 559–65. doi:10.1007/s10482-012-9840-x. PMID 23142858. S2CID 18660422.
- Turdahon M, Osman G, Hamdun M, Yusuf K, Abdurehim Z, Abaydulla G, et al. (July 2013). "Rhizobium tarimense sp. nov., isolated from soil in the ancient Khiyik River". International Journal of Systematic and Evolutionary Microbiology. 63 (Pt 7): 2424–2429. doi:10.1099/ijs.0.042176-0. PMID 23203621. S2CID 19459097.
- Wang F, Wang ET, Wu LJ, Sui XH, Li Y, Chen WX (November 2011). "Rhizobium vallis sp. nov., isolated from nodules of three leguminous species". International Journal of Systematic and Evolutionary Microbiology. 61 (Pt 11): 2582–2588. doi:10.1099/ijs.0.026484-0. PMID 21131504.
- Sayers; et al. "Rhizobium/Agrobacterium group". National Center for Biotechnology Information (NCBI) taxonomy database. Retrieved 2012-05-02.
- All-Species Living Tree Project."16S rRNA-based LTP release 106 (full tree)" (PDF). Silva Comprehensive Ribosomal RNA Database. Retrieved 2012-05-02.
- This is the type species for the genus.
- Arthrobacter viscosus is currently classified in the Micrococcaceae. See Arthrobacter.
External links
- Current research on Rhizobium leguminosarum at the Norwich Research Park
- Video and commentary on root nodules and Rhizobium in White Clover